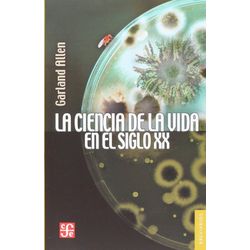

Produtos encontrados: 1 Resultado da Pesquisa por: em 1 ms
Produtos selecionados para comparar: 0Comparar
-
allen-garland
LA CIENCIA DE LA VIDA EN EL SIGLO XX - GARLAND ALLEN Sin stock NOTIFICARME CUANDO LLEGUE
Produtos encontrados: 1 Resultado da Pesquisa por: em 1 ms
Produtos selecionados para comparar: 0Comparar

